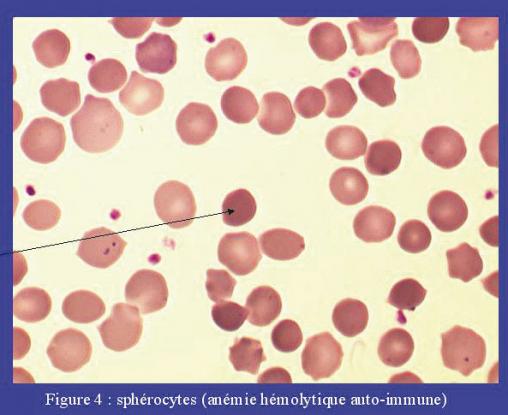

Les sphérocytes sont des globules rouges qui ont une épaisseur plus grande que la normale. Sur frottis sanguin, ils apparaissent de forme sphérique, plus foncés et plus petits que les autres. Ils sont fréquents dans les anémies hémolytiques auto-immunes et dans la sphérocytose héréditaire. La sphérocytose héréditaire, ou maladie de Minkowski-Chauffard, est la plus fréquente des anémies hémolytiques constitutionnelles par anomalie de la membrane. De transmission dominante, elle est liée à des mutations sur les gènes de différentes protéines membranaires. Ce qui entraîne une déstabilisation de portions membranaires du globule rouge, avec libération de microvésicules et diminution du rapport surface/volume érythrocytaire et une transformation de discocytes en sphérocytes
Lire aussi
Exercice
Exercice